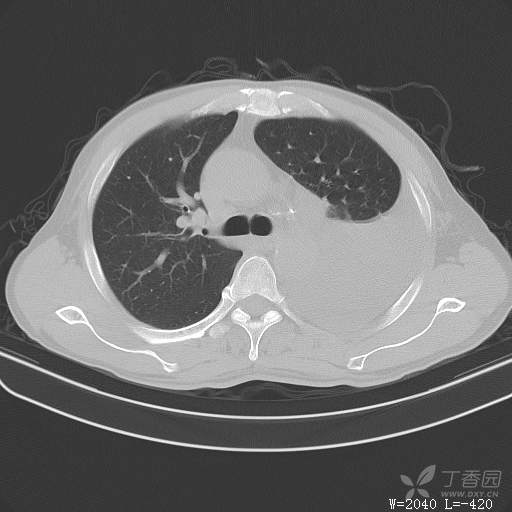
img

这个胸腔积液原因不寻常,大家猜猜看(得细心,这个很有意思)(俱乐部3)
 西门开心 +5 丁当
西门开心 +5 丁当患者性别:男
患者年龄:51
简要病史:胸闷、憋气伴低热1月
体格检查:T:37.6℃;P:92次/分;R:20次/分;Bp:100/60mmHg,神清,呼吸平稳,周身未触及肿大淋巴结,右肺及左上肺叩诊清音,左下肺叩诊浊音,右肺及左上肺呼吸音粗,左下肺未闻及呼吸音,心率92次/分,律齐,无杂音。腹部平坦,软,全腹无压痛,无反跳痛及肌紧张,肝脾肋下未触及,双下肢无水肿。
辅助检查:白细胞数目4.41 × 10^9/L,中性粒细胞百分比82.1%,*血红蛋白111g/L,*血小板数目91 × 10^9/L,凝血四项:凝血酶原时间12.5秒,国际标准化比值1.07,活化部分凝血酶原时间36.1秒,纤维蛋白原浓度6.52g/L,肾功能示:肌酐47.4umol/L,尿酸150umol/L,电解质示:钠133.5mmol/L,D-二聚体0.88mg/L,血沉67.71MM/H,C-反应蛋白114.6mg/L,肝功能:*总蛋白49.6g/L,*白蛋白27.4g/L,查胸水常规及胸水生化提示渗出液,胸水ADA154U/L,查胸水病理未见肿瘤细胞。超声:腹膜后有3~4枚肿大淋巴结,直径1~1.5厘米,余浅表淋巴结不大。
临床诊断:左侧胸腔积液
治疗经过:胸水引流。胸水白蛋白23.8克/升,乳酸脱氢酶275单位/升,胸苷激酶182单位/升,胸水外观黄色混浊,总细胞4320个/微升,白细胞4320个/微升,单核细胞80%,多核细胞20%。考虑结核性胸膜炎,结果查肿瘤标志物、胸水细胞学阴性,胸水TB—DNA阴性,结核菌素试验+,结核抗体阴性,TB-SPOT阴性,胸膜活检阴性。怎么办?
大家猜猜胸水原因是什么?